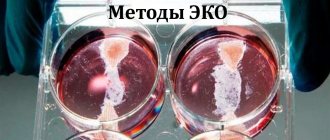

The moment of discharge of amniotic fluid
remember You should know that the discharge of amniotic fluid can occur at any stage of pregnancy, but optimally, of course, if this happens no earlier than 38 weeks, because at such a time the child is already fully ripe for birth.
Depending on the presence of labor and the degree of dilatation of the cervix, the discharge of amniotic fluid occurs:
- Premature effusion
: occurs before the onset of labor, i.e. The water broke, but there were no contractions. This option is the most undesirable, but it occurs in approximately every tenth pregnant woman; - Early outpouring
. With this option, the water breaks when regular labor is already present, but the dilation of the cervix is less than 4 cm; - Timely effusion
: occurs in the first stage of labor with regular contractions and cervical dilatation of more than 4 cm; - Delayed rupture
: rupture of the membranes occurs some time after the cervix is fully dilated.
Premature and early discharge of amniotic fluid is considered a complication, because in the absence of a fetal bladder, the child is not protected from the effects of various infectious agents. As a result, with a long anhydrous interval, infection of the fetus and internal genital organs is possible, especially if the woman suffered inflammatory diseases of the vagina, cervix, and external genital organs during pregnancy. For this reason, to prevent infectious complications, 6-8 hours after the rupture of the amniotic sac, the woman begins to be administered antibacterial drugs that do not have a negative effect on the child (ampicillin, oxacillin).
The duration of the water-free period is normal
How long can the anhydrous period during childbirth last? Everything here is individual. However, the duration of the anhydrous period during childbirth is considered to be up to 6 hours.
Women who have already had amniotic fluid leak are naturally interested in how long the baby can remain without amniotic fluid. A pathology is considered to be a water-free period of more than 72 hours. It can last from several days to several weeks, and without drug cover during such a period, complications will definitely arise in the mother and fetus.
As soon as a pregnant woman’s water breaks or there is a suspicion of leakage, she should urgently contact an obstetrician-gynecologist. After all, how long a child can be in the womb without water in a particular situation is unknown until examined by a specialist.
How amniotic fluid drains
How can you tell when your water has broken? Many women ask this question, afraid to miss this moment. To accurately recognize the situation, it is necessary to have a good knowledge of the symptoms of amniotic fluid leakage.
Amount of amniotic fluid
The question of liquid volume is quite complex, because... Water breaks in pregnant women in different ways.
If a complete rupture of the amniotic sac occurs, a fairly large amount of fluid is released at the same time (most often about 150-250 ml), so it is quite difficult to miss this option. Most often, effusion occurs at night during sleep, and the woman does not experience any sensations, simply waking up in a wet bed. If a pregnant woman is awake, she may notice a feeling of heaviness in the lower abdomen and a sensation of “popping” or “tearing inside” when the water breaks.
If the rupture of the membranes occurs high up and there is only a small hole, then water can flow out in small drops for a long time. In this case, the woman can really get confused, because... such discharge can often be attributed to excessive leucorrhoea from the genital tract or urinary incontinence. However, even a slight leak of amniotic fluid is dangerous for the baby, so if any suspicion arises, you should consult a doctor to monitor the presence or absence of amniotic fluid. In addition, you can check this yourself using special pharmacy tests.
Color and smell of amniotic fluid
Normally, amniotic fluid is clear with a small amount of impurities and has a somewhat sweet odor. If the discharged liquid is greenish, brown or black in color, this indicates the presence of meconium in it, which the fetus secretes when there is oxygen deficiency. If before birth the waters break with blood, this is an extremely dangerous sign of placental abruption and requires immediate hospitalization of the woman in the maternity ward.
Painful sensations
What are the signs of preterm labor at 33 weeks? First of all, a woman feels pain. It may have different localization. Most often, unpleasant sensations spread in the lower abdomen and lumbar region. However, there are exceptions. When the pain is periodic and cramping, these can be productive or unproductive contractions. In the first case, the woman will most likely give birth on her own. During unproductive contractions, the pain only exhausts the expectant mother without bringing any result. In such situations, doctors may use medications to stimulate the opening of the cervical canal.
When painful sensations cover the entire abdomen, and a woman feels weak, we can talk about placental abruption. This is an extremely unpleasant situation that often accompanies childbirth at 33 weeks of pregnancy. Reviews from doctors say that in this case, any delay could cost the life of the mother and her baby. This is why the maternity ward staff performs an emergency caesarean section.
What to do if your water breaks
important If a woman’s water breaks, the main thing she should do is quickly get ready and go to the maternity hospital. Under no circumstances should you stay at home and wait for contractions to start.
As mentioned above, the anhydrous interval is dangerous for the child, and labor may not begin immediately after the rupture of the membranes. When the waters have not completely broken, but only leakage is present, the woman may not give birth for a long time. In this case, while the patient is in the maternity hospital, doctors will begin to stimulate labor, which will help reduce the anhydrous gap.
In addition, after the discharge of amniotic fluid, the woman must be examined in a gynecological chair.
dangerous The fact is that along with the water, the umbilical cord may fall out, which is extremely dangerous: when it is compressed, asphyxia and death of the fetus quickly occurs. If the doctor is unable to set the umbilical cord back, the woman will have an emergency caesarean section.
It is also possible for small parts of the fetus to fall out (arms, legs), which will lead to disruption of labor and the impossibility of inserting the presenting part of the fetus into the pelvic cavity.
A pregnant woman, especially, should be urgently hospitalized if the amniotic fluid is “bad” with the presence of impurities in it.
Possible complications at 32 weeks of pregnancy
One of the possible complications of pregnancy is postpartum obesity, metabolic syndrome and the subsequent development of diabetes. To prevent such dangerous conditions, a woman needs to carefully monitor her weight.
Another danger is a lack of calcium. When there is a deficiency of this element, it begins to be washed out of the walls of blood vessels. This increases the risk of hemorrhoids and varicose veins. A lack of vitamin D can lead to the development of rickets in a child.
A very serious complication of pregnancy is preeclampsia. It is manifested by protein in the urine, high blood pressure and the occurrence of edema. With this pathology, the functioning of many organs of the mother’s body is disrupted, including the placenta, which negatively affects the condition of the fetus. The initial form of preeclampsia in modern gynecology is considered separately, as gestosis or late toxicosis. There is no effective treatment method for this pathology today. Medical care boils down to constant monitoring of the woman and alleviation of her symptoms. If the pregnancy is less than 34 weeks at diagnosis, the woman receives corticosteroid injections. They accelerate the maturation of the baby’s lungs, preparing him for possible delivery ahead of schedule. In the most severe cases, a life-threatening condition develops - eclampsia, which is manifested by seizures.
Polyhydramnios and oligohydramnios pose a great danger at this stage, since they can cause certain malformations of the fetus. It is important to diagnose such conditions in a timely manner. Possible signs of polyhydramnios or oligohydramnios:
Nausea and even vomiting;
Feeling weak;
Water leakage;
Drawing pain in the lower abdomen.
If suspicious symptoms appear, go to the hospital immediately. The doctor will examine you and prescribe the necessary examinations.
Due to the growth of the abdomen, a woman’s center of gravity shifts. Therefore, pregnant women are often bothered by pain in the sides, hypochondrium and lower back. To reduce discomfort, you need to wear a bandage, lie on a hard mattress, and do special exercises for your back muscles.
Low blood pressure may cause headaches. It is prohibited to remove them using medications. It is better to resort to traditional methods - sweet tea with lemon or parsley will help you. Also try to walk more in the fresh air.
If you have a cold, do not self-medicate. It is better to consult a gynecologist who can choose safe medications for you to treat colds during pregnancy.
Absence of contractions after rupture of amniotic fluid
As a rule, labor begins within 3-4 hours after the rupture of amniotic fluid. If contractions do not begin, then the question of starting labor stimulation is raised.
The time issue in this situation is widely discussed and becomes the subject of dispute among various experts. For example, in many European countries they choose the waiting method: artificial stimulation begins only one day after the rupture of the membranes. In Russia, the deadline is considered to be 12 hours of absence of labor, but at the same time, many obstetrician-gynecologists try not to wait that long due to the high risk of infection of the child and begin stimulation earlier.
Most women, of course, strive for a natural course of labor without the use of various medications, but it should be understood that in such a situation one should not argue with a specialist. Waiting can be dangerous and sometimes lead to disastrous consequences.
Consequences for the child during premature birth
How can childbirth at 33-34 weeks of pregnancy end for a child? At this stage of development, every day or even hour spent in the womb is important for the baby. This is why doctors try so hard to keep a woman pregnant, even for a few days.
If the expectant mother goes to the maternity ward on time, the specialists will have time to administer certain medications to her before giving birth. They will be aimed at maintaining the independent functioning of the child’s organs. The appearance of the baby at 6 months, as well as the birth at 33 weeks, reviews are quite favorable. Approximately 90 percent of babies born at this stage of development not only survive, they can breathe on their own. Some children still require intensive therapy. Many of them continue to be fed through a tube for some time.
Thermoregulation of premature babies has not yet been established. Any hypothermia or overheating can lead to unpleasant consequences. That is why it is so important to provide timely help to the baby. Doctors place the babies in special incubators. There, all conditions are provided for children: the required temperature is maintained, they have the opportunity to receive food and the necessary medications. In the absence of congenital pathologies, children can be next to their mother in 2-4 weeks.
Often premature babies are deprived of natural nutrition. While the babies are under medical supervision, the mother simply loses her breast milk. To prevent this from happening, you should contact a lactation consultant immediately after giving birth. A specialist will tell you when and how to express milk correctly, so that later you will be able to feed your baby on your own. After all, it is this food that will allow the crumbs to quickly adapt to the environment.
Separately, it is worth mentioning the premature birth of boys. If your son was born at 33 weeks, his testicles most likely have not yet descended into the scrotum. There is nothing terrifying about this. There is no need to create panic. Usually, within a month or two after proper care, the baby’s reproductive organs take their usual position. However, there are exceptions. Be sure to consult a surgeon so that the doctor can take your situation under his own control. If necessary, surgery may be necessary after some time.
Comments (2)
- Lisa November 19, 2020 20:05
Hello! I'm about to give birth and I'm very worried that my water won't break in time when contractions start and it's time to go to the hospital. What to do then? - Baby-Calendar 19 November 2020 21:20
Don't worry. If, after the onset of labor, the waters do not break naturally, an amniotomy will be performed - a painless procedure for puncturing the amniotic sac. Remember that only a specialist in a hospital can carry it out.
The contractions started, but the waters did not break - how to help the waters break: piercing
This happens quite often. It's quite normal. For many women in labor, the bladder may remain intact until the actual pushing. That is, there are contractions, but the water does not flow out. In such cases, the bladder is punctured. The procedure is absolutely painless and harmless. A small hook-like probe is inserted through the cervix. He pierces the shell. After effusion, contractions may become more frequent, and labor will become more active.
The contractions started, but the waters did not break - how to help the waters break: piercing
Why do pregnant women's waters turn green? Is it dangerous?
Green waters are abnormal and indicate danger. Most often this is an alarming symptom. The green color often appears due to the fact that the baby's first stool gets into the water.
Causes of green waters:
- Genetic diseases of the child
- Maternal genital tract infections
- Old placenta
- Post-term baby
- Oxygen starvation of the baby
Why do pregnant women's waters turn green? Is it dangerous?